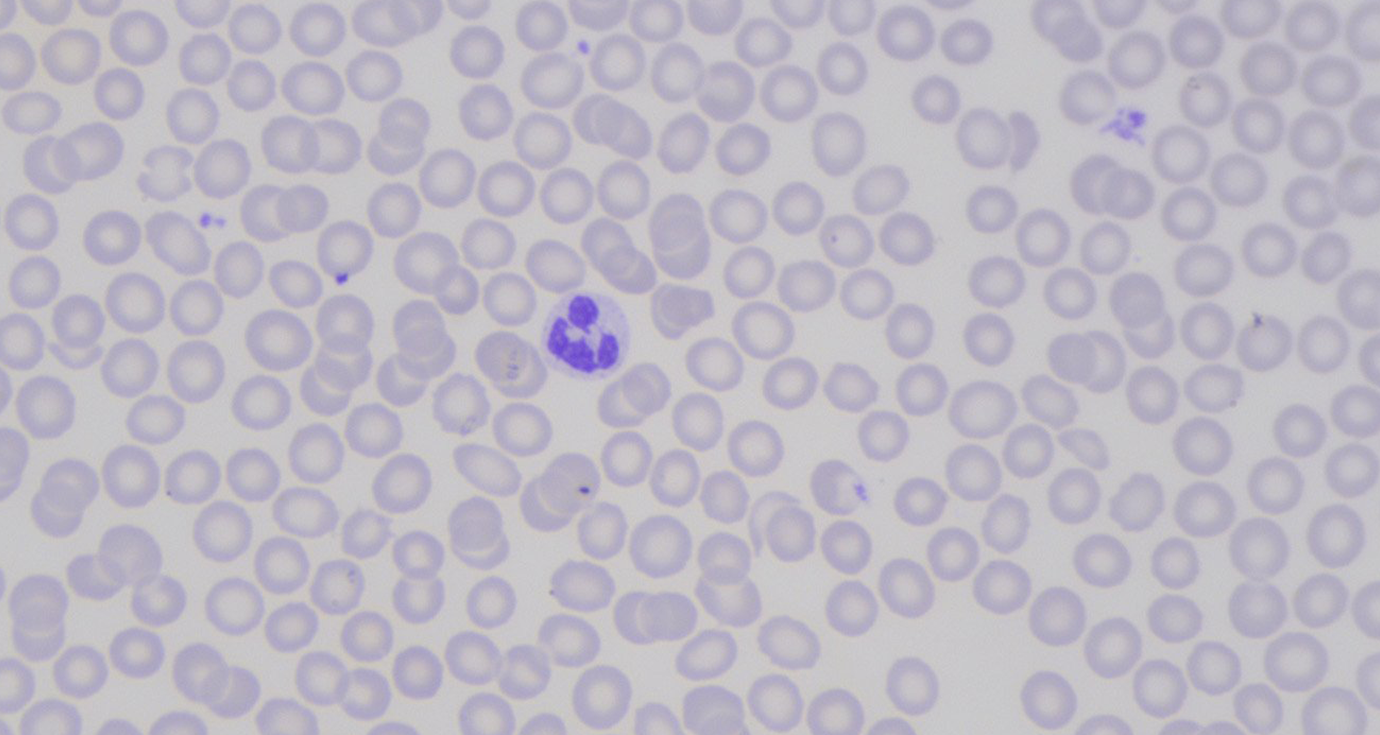
Immagine con regolazione del colore magenta nell'Operatore a 6 Assi
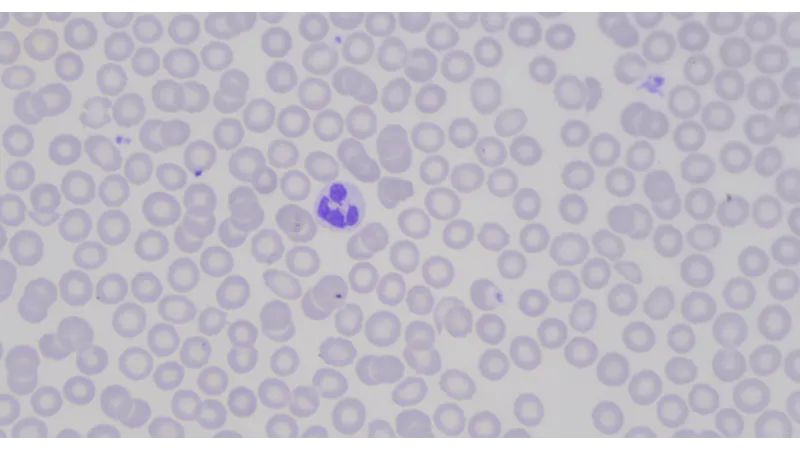
Immagine con regolazione del colore magenta nell'Operatore a 6 Assi
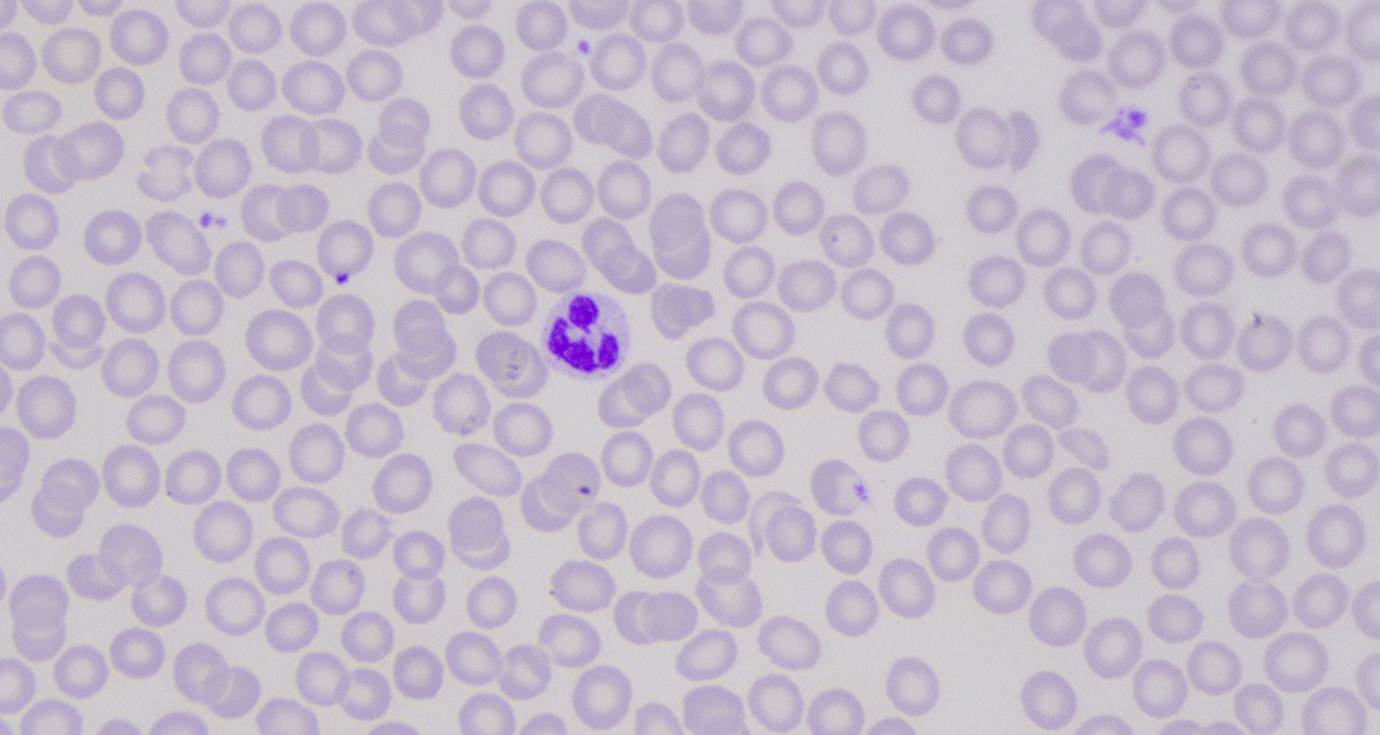
Immagine con regolazione del colore magenta nell'Operatore a 6 Assi
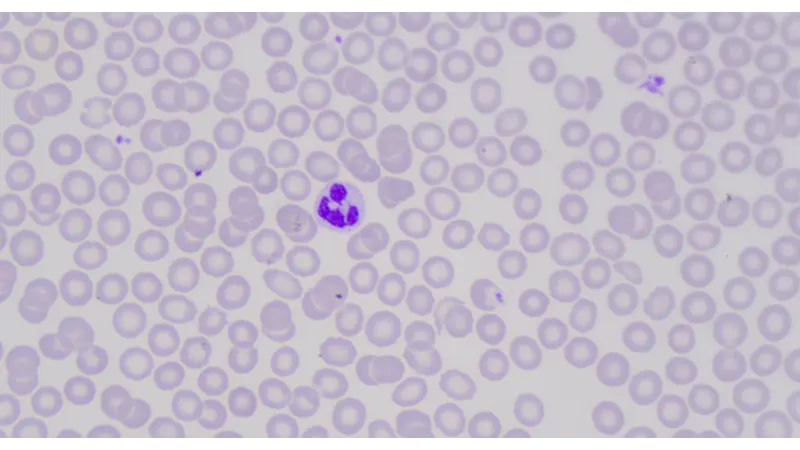
Immagine con regolazione del colore magenta nell'Operatore a 6 Assi

Perfect Color - Impostazioni del colore facili e flessibili
Per ottenere la giusta impressione cromatica, le applicazioni Medical & Life Sciences richiedono impostazioni cromatiche individuali e precise. Questo perché le immagini costituiscono la base per le decisioni mediche in microscopia e oftalmologia, ad esempio. La configurazione del colore è spesso complessa e richiede molto tempo. Il Feature Set Perfect Color di Basler MED alleggerisce il lavoro, quando possibile, grazie a preimpostazioni e strumenti pratici, ma allo stesso tempo lascia spazio a regolazioni individuali.
I vantaggi di Perfect Color
Calibratore del colore Basler per la massima fedeltà cromatica con pochi clic del mouse
Regolazione comoda di tonalità, saturazione, luminosità e contrasto per controllare l'intero spazio colore.
Operatore a 6 assi brevettato per la regolazione indipendente dei singoli colori nello spazio cromatico
Preimpostazioni di colore selezionabili per diverse sorgenti luminose
Basler Color Calibrator: calibrazione del colore semplificata
La riproduzione del colore è estremamente importante per le immagini mediche delle scienze della vita. Le telecamere devono avere le giuste impostazioni per ottenere la migliore fedeltà cromatica, ossia il minimo errore di colore derivante dall'immagine reale e dalla proiezione digitale. Tuttavia, la ricerca delle impostazioni cromatiche "perfette" è complicata. Lo strumento di calibrazione del colore Basler nel software pylon offre una soluzione semplice e rapida per questo compito altrimenti complesso.
Impostazioni individuali dell'intero spazio colore per una flessibilità del 100%.
Applicazioni diverse richiedono impostazioni cromatiche diverse. Il Feature Set Perfect Color di MED offre la possibilità di effettuare impostazioni per controllare l'intero spazio colore. Tonalità, saturazione, luminosità e contrasto possono essere regolati manualmente in base alle esigenze individuali.



Operatore Basler a 6 assi: impostare ogni colore individualmente
A volte la regolazione di un solo colore è necessaria per ottenere la perfetta impressione cromatica di un'immagine. Questo non rappresenta un problema grazie all'Operatore a 6 assi brevettato da Basler. Questo strumento consente di impostare i singoli colori. Poiché viene eseguito sull'FPGA della telecamera, consente di risparmiare importanti risorse sul sistema host dei nostri clienti.

Le preimpostazioni di colore per i diversi sistemi di illuminazione consentono di risparmiare tempo e fatica.
La tua applicazione lavora con una sorgente luminosa standard? Il Feature Set Perfect Color di MED offre preset di colore ottimizzati per le sorgenti luminose più comuni. Oltre alle impostazioni collaudate per l'elaborazione delle immagini industriali, sono integrate sorgenti luminose comuni come il LED del microscopio Olympus (4500 K e 6000 K) o il LED del microscopio Leica (5500 K) per le applicazioni di microscopia. Risparmia tempo e fatica scegliendo le preimpostazioni di colore per la tua illuminazione.